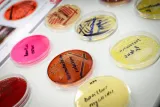
dsc5448130190.jpg

Published: 28.01.2026
Fakulta chemicko-technologická Univerzity Pardubice ožila v pátek 23. a v sobotu 24. ledna tradičními Dny otevřených dveří.
Program po oba dny zahájila paní proděkanka doc. Ing. Alena Komersová, Ph.D., která ve své úvodní přednášce v Posluchárně Jana Palacha seznámila návštěvníky s naší fakultou a nabídkou studijních programů pro akademický rok 2026/2027. Ještě před samotným začátkem přicházeli první návštěvníci do naší relax zóny a následné dotazy od budoucích studentů naznačily, že i o letošní ročník bude velký zájem.
A jak to u nás tedy vypadalo?
Vysoká účast: Celkem k nám dorazilo přes 600 návštěvníků.
Studium z první ruky: Návštěvníci získali kompletní přehled o studijních programech a o životě a studiu na fakultě si popovídali přímo s vyučujícími i současnými studenty.
Exkurze do laboratoří: Velký úspěch sklidily prohlídky našich laboratoří a vědeckých center, kde probíhá výuka i výzkum.
Chvilka klidu: Pro načerpání sil byla připravena relaxační zóna s kávou a občerstvením, která přišla po nabitém programu vhod.
Máme velkou radost z tak vysokého zájmu a věříme, že se s mnohými z vás uvidíme znovu v září u zápisu do prvního ročníku. Obrovské díky patří celému týmu zaměstnanců fakulty. Právě díky jejich nasazení, profesionálnímu přístupu a dobré náladě se podařilo vytvořit skvělou atmosféru po oba dny.
Děkujeme všem za návštěvu, byli jste skvělí!
foto Milan Reinberk